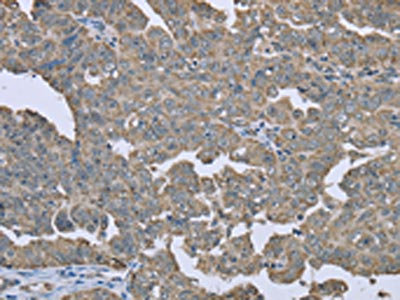

ESR2 Antibody
-
中文名稱:ESR2兔多克隆抗體
-
貨號(hào):CSB-PA912176
-
規(guī)格:¥1100
-
圖片:
-
The image on the left is immunohistochemistry of paraffin-embedded Human cervical cancer tissue using CSB-PA912176(ESR2 Antibody) at dilution 1/20, on the right is treated with fusion protein. (Original magnification: ×200)
-
The image on the left is immunohistochemistry of paraffin-embedded Human ovarian cancer tissue using CSB-PA912176(ESR2 Antibody) at dilution 1/20, on the right is treated with fusion protein. (Original magnification: ×200)
-
Gel: 8%SDS-PAGE, Lysate: 40 μg, Lane: Mouse brain tissue, Primary antibody: CSB-PA912176(ESR2 Antibody) at dilution 1/250, Secondary antibody: Goat anti rabbit IgG at 1/8000 dilution, Exposure time: 10 seconds
-
-
其他:
產(chǎn)品詳情
-
Uniprot No.:
-
基因名:
-
別名:ER BETA antibody; ER-beta antibody; Erb antibody; ESR B antibody; ESR BETA antibody; ESR2 antibody; ESR2_HUMAN antibody; ESRB antibody; ESTRB antibody; estrogen nuclear receptor beta variant a antibody; estrogen nuclear receptor beta variant b antibody; estrogen receptor 2 (ER beta) antibody; Estrogen receptor 2 antibody; estrogen receptor beta 4 antibody; Estrogen receptor beta antibody; NR3A2 antibody; Nuclear receptor subfamily 3 group A member 2 antibody
-
宿主:Rabbit
-
反應(yīng)種屬:Human,Mouse,Rat
-
免疫原:Fusion protein of Human ESR2
-
免疫原種屬:Homo sapiens (Human)
-
標(biāo)記方式:Non-conjugated
-
抗體亞型:IgG
-
純化方式:Antigen affinity purification
-
濃度:It differs from different batches. Please contact us to confirm it.
-
保存緩沖液:-20°C, pH7.4 PBS, 0.05% NaN3, 40% Glycerol
-
產(chǎn)品提供形式:Liquid
-
應(yīng)用范圍:ELISA,WB,IHC
-
推薦稀釋比:
Application Recommended Dilution ELISA 1:1000-1:2000 WB 1:200-1:1000 IHC 1:25-1:100 -
Protocols:
-
儲(chǔ)存條件:Upon receipt, store at -20°C or -80°C. Avoid repeated freeze.
-
貨期:Basically, we can dispatch the products out in 1-3 working days after receiving your orders. Delivery time maybe differs from different purchasing way or location, please kindly consult your local distributors for specific delivery time.
-
用途:For Research Use Only. Not for use in diagnostic or therapeutic procedures.
相關(guān)產(chǎn)品
靶點(diǎn)詳情
-
功能:Nuclear hormone receptor. Binds estrogens with an affinity similar to that of ESR1/ER-alpha, and activates expression of reporter genes containing estrogen response elements (ERE) in an estrogen-dependent manner.; Lacks ligand binding ability and has no or only very low ERE binding activity resulting in the loss of ligand-dependent transactivation ability.
-
基因功能參考文獻(xiàn):
- An association was found between the rs1256032 polymorphism of estrogen receptor beta gene and reduced risk in a Mexican population of developing type 2 diabetes. PMID: 29666032
- We identified a homozygous ESR2 variant, c.541_543del p.(Asn181del) in the highly conserved DNA-binding domain of ER-beta in an individual with syndromic 46,XY DSD. Two additional heterozygous missense variants, c.251G>T p.(Gly84Val) and c.1277T>G p.(Leu426Arg), located in the N-terminus and the ligand-binding domain of ER-beta, were found in unrelated, nonsyndromic 46,XY DSD cases. PMID: 29261182
- therapeutic activation of ERbeta elicits potent anticancer effects in Triple-negative breast cancer through the induction of a family of secreted proteins known as the cystatins, which function to inhibit canonical TGFbeta signaling and suppress metastatic phenotypes both in vitro and in vivo. PMID: 30257941
- ESR2 polymorphisms demonstrate minimal influence on Bone mineral density changes in women. PMID: 29320918
- Low ESR2 expression is associated with Tumor Progression in Colorectal Cancer with Familial Adenomatous Polyposis and Sporadic Polyps. PMID: 28681123
- The possible role of ESR2 G1730A variant as the risk factor of MI in a young age. PMID: 30036658
- TCF21 modulates Steroidogenic factor-1 and estrogen receptor beta expression through the recruitment of USF2 in endometriotic stromal cells. PMID: 30018006
- High phosphorylated ESR2 expression is associated with pancreatic ductal adenocarcinoma. PMID: 30046904
- FSHR rs6165, not ESR2 rs4986938, could be suggested as a candidate marker to predict poor ovarian response. PMID: 29036809
- There was a significant association between ERbeta RsaI and postmenopausal osteoporosis risk in both overall and Asian populations PMID: 29458346
- Estrogen receptor beta1 activation accelerates resistance to epidermal growth factor receptor-tyrosine kinase inhibitors in non-small cell lung cancer. PMID: 29328407
- Increased cytoplasmic ERbeta1 and nuclear ERbeta2 expression is associated with worse cancer specific outcomes following radical prostatectomy. These findings suggest that tumor ERbeta1 and ERbeta2 staining patterns provide prognostic information on patients treated with radical prostatectomy. PMID: 26804755
- ESR2 single nucleotide polymorphism is associated with poor ovarian response in Egyptian women undergoing IVF procedure. PMID: 28825151
- ERbeta expression conferred cell sensitivity, as patient-derived AML cells with high levels of ERb were sensitive, whereas cells with low ERb were insensitive to diosmetin. Knockdown of ERb confirmed resistance, whereas overexpression enhanced sensitivity to diosmetin, which was demonstrated to be mediated by reactive oxygen species signaling. PMID: 28835383
- Data report for the first time that ERbeta inversely regulates miR-10b and miR-145, which are critical modulators of functional properties, epithelial to mesenchymal transition and extracellular matrix composition of breast cancer cells. ERbeta together with miR-10b and miR-145, are key players for the initiation of breast cancer cell aggressiveness. PMID: 28797712
- the mRNA expression levels of ERbeta isoforms are downregulated in sporadic colorectal cancer and in FAP individuals. T3/T4 tumours also presented decreased expression of ERbeta. Additionally, the expression levels of ERbeta1 and ERbeta5 were associated with the probability of disease-free survival. PMID: 29132333
- factors that regulate the alternative splicing of ERs remain unknown. We demonstrate novel evidence supporting a potential biological feedback loop where 17beta-estradiol regulates the RNA-binding protein Nova1, which, in turn, regulates the alternative splicing of ERbeta PMID: 29031089
- A dual role of the association between AGO2 and ERbeta in luminal-like breast cancer cells in the nucleus and the cytoplasm, for the regulation of gene expression at both the transcriptional and post-transcriptional level. PMID: 29017520
- We found higher nuclear (n)ERalpha and nERbeta5 and lower cytoplasmic (c)ERalpha expression in advanced ovarian cancers. Lower ERbeta1 expression was also detected in high grade cancers. Loss of nERalpha and cERbeta2 expression were observed in clear cell histological subtypes. Higher nERbeta5 and lower cERbeta5 expression were associated with serous/clear cell subtypes, poor disease-free and overall survival. PMID: 28859612
- We found little overall difference in the DNA methylation of the ESR2 5'-flanking region in individuals with autism compared with normal individuals. PMID: 28299627
- our data reveal a novel mechanism for ERbeta's anti-proliferative and pro-apoptotic effects in breast cancer cells involving p53 and epigenetic changes in histone methylation that underlie gene regulation of these cellular activities. PMID: 28577282
- loss of ERbeta function acts in collaboration with p53 inactivation to induce early onset of mammary tumors with spindle cell morphology and more basal-like characteristics. PMID: 28673316
- Low levels of ESR2 is associated with metastasis in triple-negative breast cancer. PMID: 28583190
- Findings from the systematic review and meta-analysis suggest that rs1256120 of ESR2 is unlikely to be a predisposing or disease-modifying genetic risk factor for adolescent idiopathic scoliosis. PMID: 27755497
- High concentrations of DINCH urinary metabolites activate human ESR2 receptors. PMID: 29421333
- Tumor ERbeta1 expression was available for 911 breast cancer patients and was not associated with ESR2 genotypes. High tumor ERbeta1 expression is a marker of good prognosis in breast cancer, especially among chemotherapy-treated patients, but not in endocrine therapy-treated patients. PMID: 27810901
- Targeting ERbeta with selective agonists might affect Hodgkins lymphoma cell proliferation and tumor growth via a mechanism that brings into play DRAM2-dependent autophagic cascade. PMID: 28052027
- ERbeta might be the target protein of arctigenin responsible for inhibition of mTORC1 activation and resultant prevention of Th17 cell differentiation and colitis development. PMID: 27863380
- Data suggest that the ERalpha-H19-BIK signaling axis plays an important role in promoting breast cancer cell chemoresistance. PMID: 27845892
- fulvestrant up-regulated ERbeta in ERalpha+/ERbeta+ breast cancer and in triple negative ERbeta+ breast cancers (ERalpha-/ERbeta+) PMID: 27486755
- ERbeta plays a crucial role in the cell behavior and extracellular matrix composition of the highly aggressive MDA-MB-231 cells. PMID: 27179695
- Study provides evidence for a critical role of ESR2 in radio-resistance of in head and neck squamous cell carcinoma, and that SMR3A might serve as a surrogate marker for active ESR2 signaling. PMID: 28166815
- This study demonstrated that ESR2 but not ESR1 minor alleles were associated with lower cognitive performance in elderly women with an indication of a gene-gene interaction with APOEepsilon4. And also found indications for gene-environment interactions of ESR2 with traffic-related air pollution exposure on cognitive performance. PMID: 27629499
- LY500307 is a highly selective estrogen receptor beta agonist, which loses its selectivity at high dose and leads to undesirable suppression of total testosterone concentration. PMID: 27136911
- ERbeta ubiquitination, protein turnover, and inhibition of breast cancer is regulated by tyrosine phosphorylation PMID: 27323858
- ERbeta in both normal and cancerous colon epithelial cells upregulates miRNA-205, which subsequently reduces PROX1 through direct interaction with its 3'UTR PMID: 27283988
- Membrane estrogen receptor beta and GPER signaling mediate cellular responses to environmentally relevant concentrations of CdCl2 and NaAsO2 in lung adenocarcinoma cells. PMID: 27071941
- C-Jun and CREB are recruited to ESR2 or CYP19A1 promoter by IGF-I stimulation. PMID: 26899323
- increases in ERbeta and p53 immunoreactivity were significantly correlated with the incidence of metastasis and/or recurrence in endometrial endometrioid carcinoma PMID: 29190668
- Low estrogen receptor beta is associated with triple-negative breast cancer. PMID: 26871946
- The variation at rs10144225 in ESR2 was associated with salt-sensitive blood pressure (SSBP) in premenopausal women (estrogen-replete) and not in men or postmenopausal women (estrogen-deplete). Inappropriate aldosterone levels on a liberal salt diet may mediate the SSBP. PMID: 28938457
- Data suggest that 17-beta-estradiol/ESR2 signaling counteracts TNFA-induced, inflammation-mediated apoptosis of vascular endothelial cells in a mechanism that requires NOTCH1-mediated Akt phosphorylation. (ESR2 = estrogen receptor 2; TNFA = tumor necrosis factor-alpha; NOTCH1 = Notch homolog 1, translocation-associated protein) PMID: 28893903
- Expression of ERbeta and p53 significantly correlated with age and advanced cancer stages, and the p53-negative EOGC was associated with favorable outcomes. PMID: 27781410
- Our data suggest that oestrogens stimulated osteogenic differentiation in human dental pulp cells and that this action is mediated principally through the ERbeta isoform PMID: 29031686
- ESR2 may modify the interaction between negative life events and MDD in the Chinese Han menopausal females. PMID: 27814959
- Results show that ERb is upregulated in bladder malignant tissue, and its expression is associated with muscle-invasive disease. PMID: 27324053
- estrogen may play a role in androgen-independent prostate cancer cell proliferation through a novel pathway, involving ERbeta-mediated activation of beta-catenin. PMID: 27107935
- ERbeta immunoreactivity was markedly present in all the cases of Merkel cell carcinoma examined. significant correlation with Ki-67 labeling index and Bcl-2 score suggest that ERbeta could be associated with regulation of both cell proliferation and apoptosis in MCCs. PMID: 27343835
- Germline ESR2 mutation is associated with medullary thyroid carcinoma. PMID: 26945007
- Exposure to the combination of 100 muM genistein and 10 nM calcitriol reduced the number of proliferative cells to control levels, increased ERb and VDR expression, and reduced extracellular acidification (40%) as well as respiratory activity (70%), primarily in MG-63 cells..strong overexpression SGPL1, which irreversibly degrades sphingosine-1-phosphate thereby, generating ethanolamine PMID: 28125641
顯示更多
收起更多
-
亞細(xì)胞定位:Nucleus.
-
蛋白家族:Nuclear hormone receptor family, NR3 subfamily
-
組織特異性:[Isoform 1]: Expressed in testis and ovary, and at a lower level in heart, brain, placenta, liver, skeletal muscle, spleen, thymus, prostate, colon, bone marrow, mammary gland and uterus. Also found in uterine bone, breast, and ovarian tumor cell lines, b
-
數(shù)據(jù)庫(kù)鏈接:
Most popular with customers
-
-
YWHAB Recombinant Monoclonal Antibody
Applications: ELISA, WB, IHC, IF, FC
Species Reactivity: Human, Mouse, Rat
-
Phospho-YAP1 (S127) Recombinant Monoclonal Antibody
Applications: ELISA, WB, IHC
Species Reactivity: Human
-
-
-
-
-